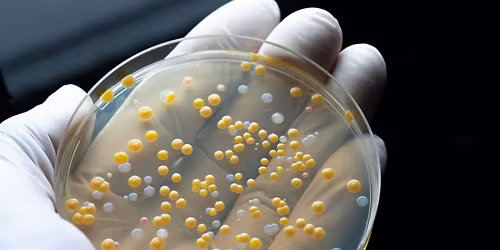
UM Knowledge Exchange -  Microscopic World

✨ Embark on an extraordinary journey at It Takes Two - A Tribute to Rod Stewart and Tina Turner, where every moment promises to be unforgettable! 🌟 Imagine of transforming Event Centre At Club Regent Casino in the heart of Winnipeg, MB into a realm of endless possibilities. 📅 Join us on March 26th, 2026 at 06:00 PM for an experience that will challenge your imagination and exceed your expectations. 🎯 This carefully curated event combines the finest elements of entertainment, innovation, and community spirit. Whether you're an adventure seeker, culture enthusiast, or someone looking for unique experiences, this event offers something special for everyone. 🎊 Don't miss this chance to be part of something extraordinary!http://maps.seatics.com/EventCentreAtClubRegentCasino_EndStage_2024-05-08_2024-05-08_0148_05082024_015847_SVGC_tn.png
Event Venue
Event Centre At Club Regent Casino, 1425 Regent Ave. W., Winnipeg, Canada
Tickets
Concerts, fests, parties, meetups - all the happenings, one place.